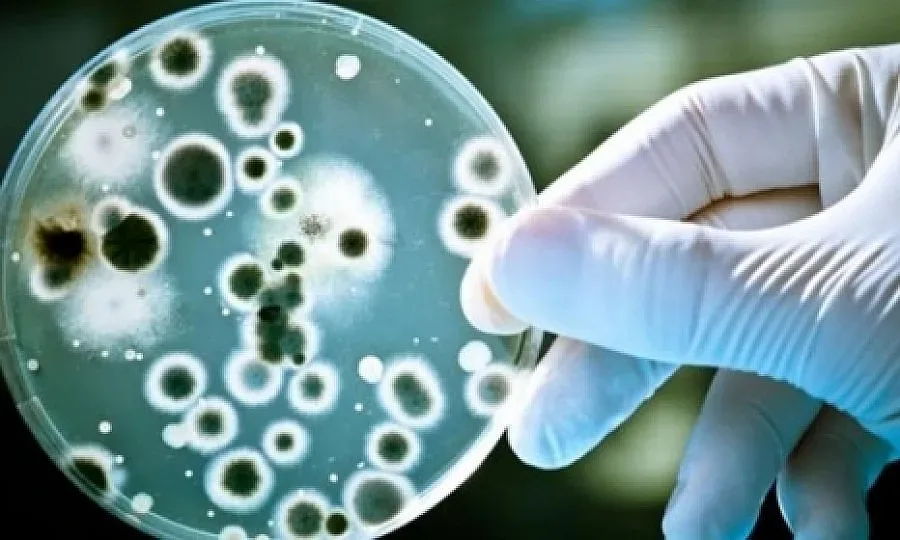
Огнище на антракс в село Еленово

Огнище на антракс в село Еленово, община Попово, област Търговище. Експерти от Областна дирекция по безопасност на храните са взели проба от теле с влошено здравословно състояние, намиращо се в землището на населеното място. Лабораторните резултати са потвърдили наличието на болестта, съобщиха от пресцентъра на Българската агенция по безопасност на храните.
ОДБХ - Търговище съвместно с Регионална здравна инспекция – Търговище продължават обследването на случая.
Всичките възприемчиви животни в селото, 329 говеда и 533 овце ще бъдат ваксинирани. Животновъдният обект ще бъде дезинфекциран, а трупът на заболялото животно ще бъде обезвреден на екарисаж, уточниха от агенцията.
Към момента няма данни за заболели хора. Предстои свикване на Областна епизотична комисия за обявяване на мерки за неразпространение на болестта, сочи още информация на РЗИ – Търговище.
Последвайте ни в Google News Showcase за важните новини
Вижте всички актуални новини от Standartnews.com